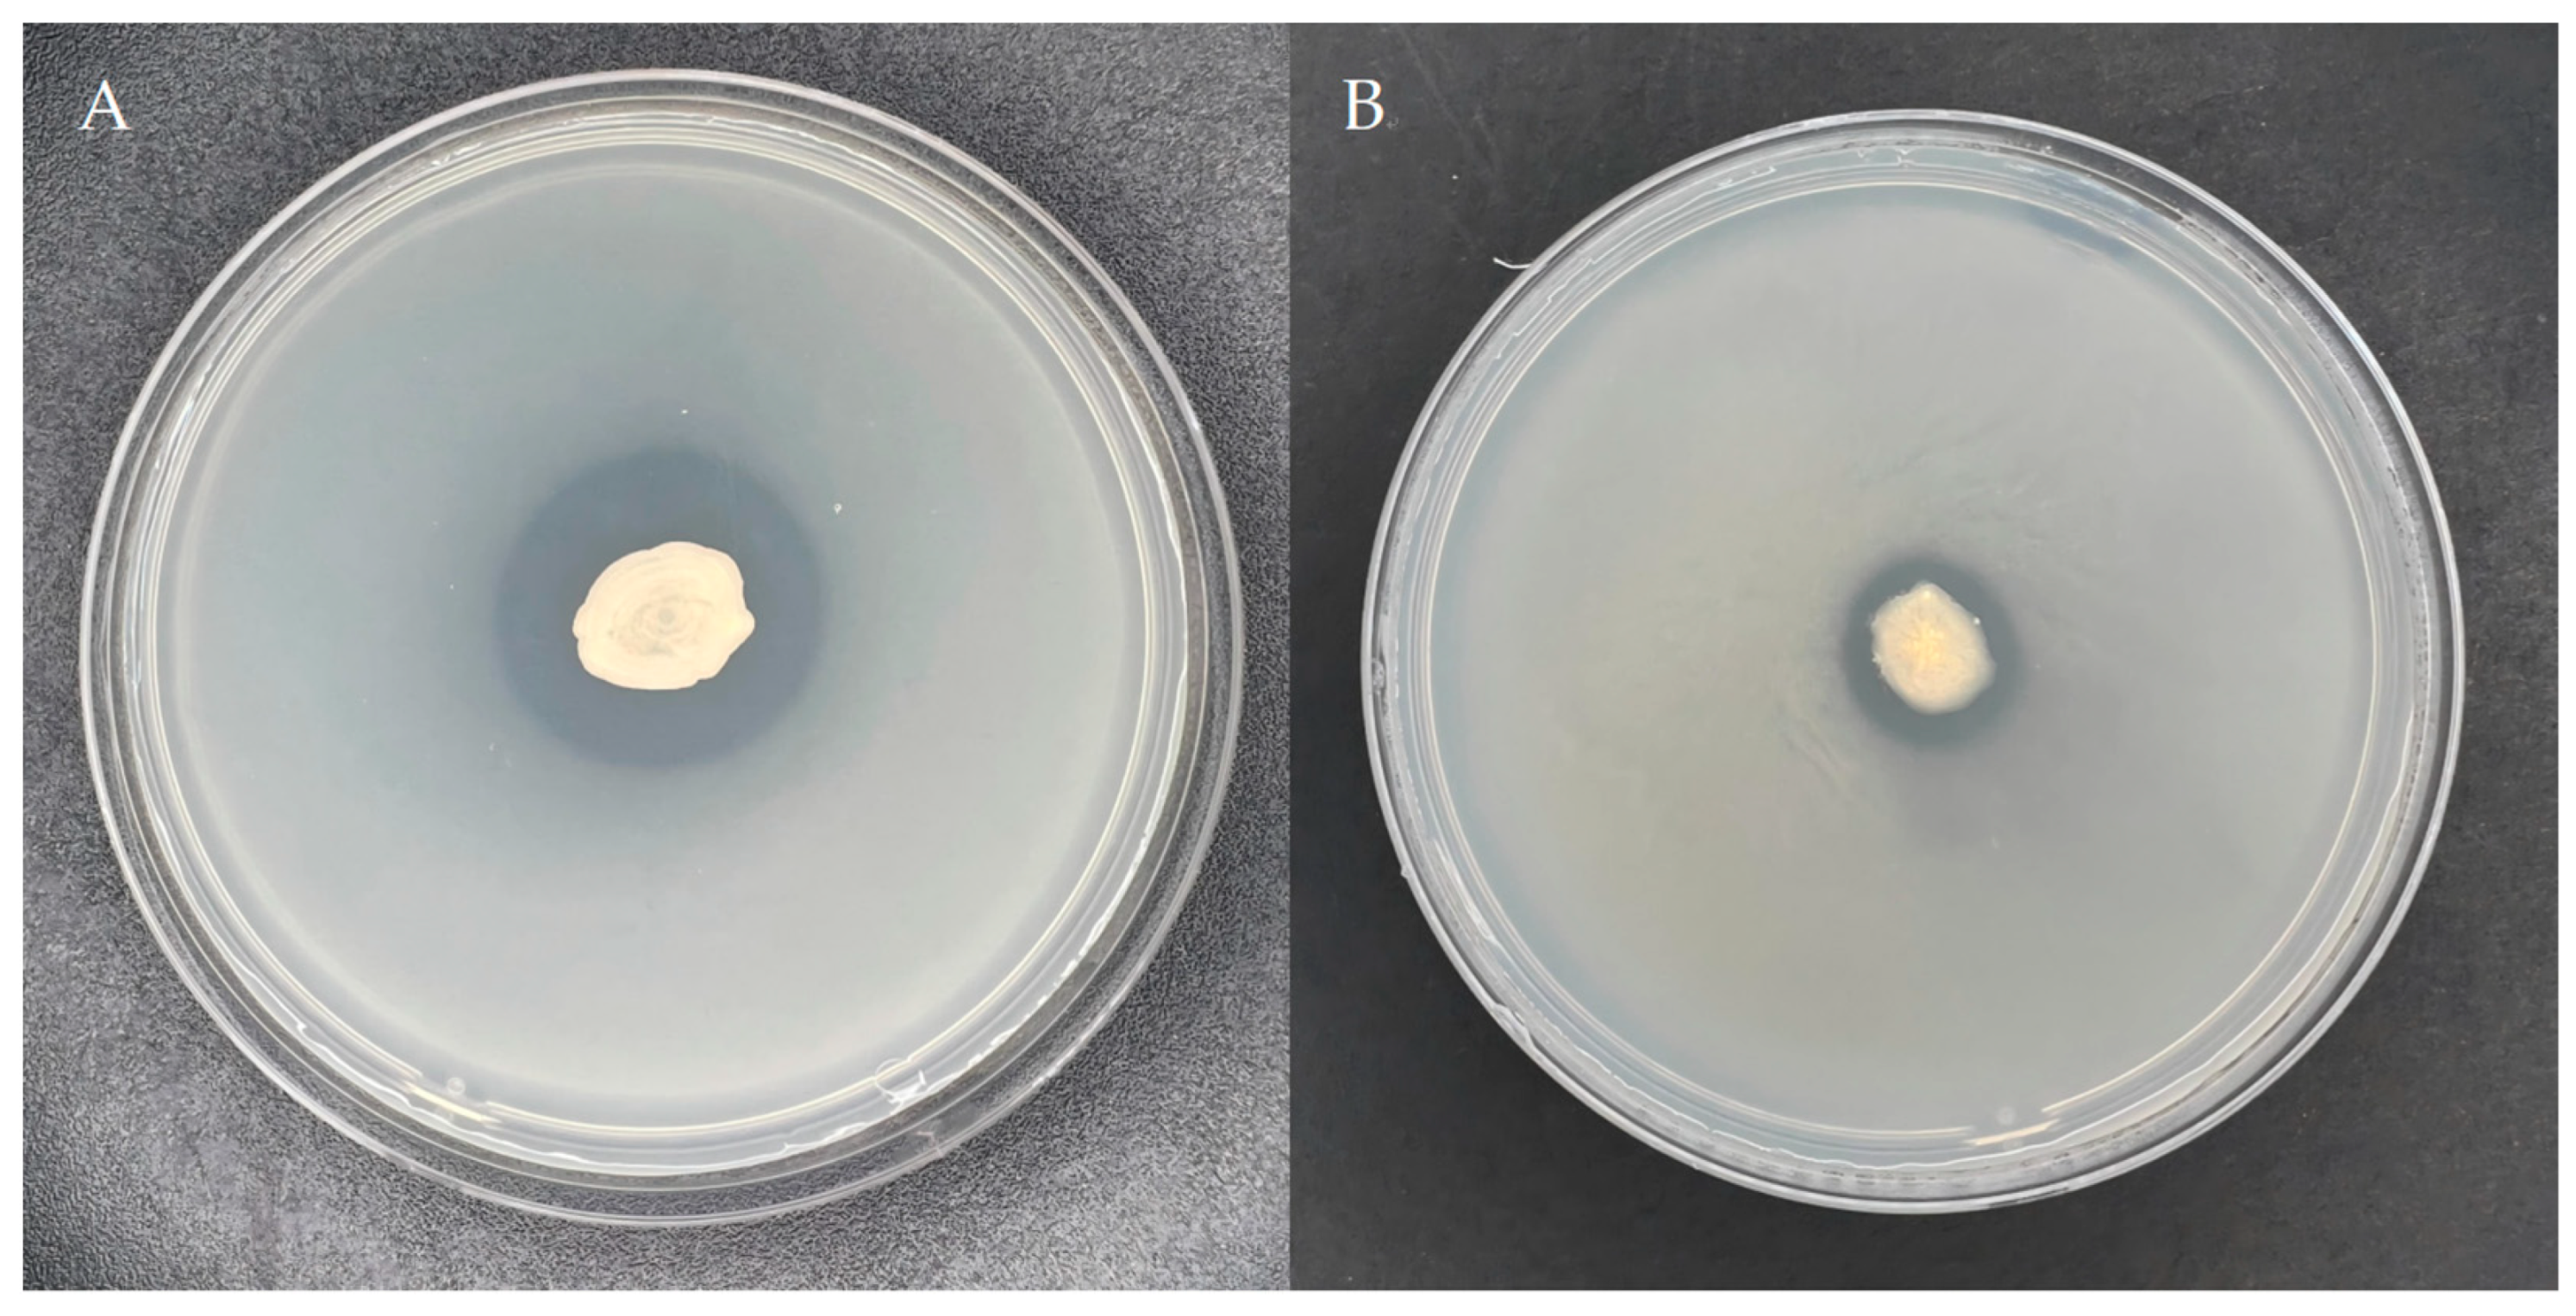
Microorganisms 13 01244 g001

Screening, Identification, and Fermentation of Brevibacillus laterosporus YS-13 and Its Impact on Spring Wheat Growth
Abstract
1. Introduction
2. Materials and Methods
2.1. Characteristics and Identification of the Strain
2.2. Evaluation of Phosphate-Solubilizing Capacity
2.3. Phosphate-Solubilizing Characteristics of the Strain Across Different Phosphorus Sources
2.4. Experimental Design and Process Optimization
2.5. Design of the Pot Experiment
2.6. Growth Index Determination
2.7. Statistical Analyses
3. Results
3.1. Strain Identification and Phosphate-Solubilizing Capacity
3.1.1. Isolation and Screening of Phosphate-Solubilizing Strains
3.1.2. Phosphate-Solubilizing Capacity of the Strain YS-13
3.1.3. Phosphate-Solubilizing Capacity of the Strain YS-13 with Various Phosphorus Sources
3.1.4. Morphological Characterization of the Strain YS-13
3.1.5. Physiological and Biochemical Profiling of the Strain YS-13
3.1.6. Molecular Characterization of the Strain YS-13
3.2. Optimization of Fermentation Conditions
3.3. Impact of B. laterosporus YS-13 Inoculant on Wheat Growth
3.3.1. Effect of B. laterosporus YS-13 at Different Concentrations on Plant Height
3.3.2. Effect of B. laterosporus YS-13 at Different Concentrations on the Fresh Weight of Plants
3.3.3. Effect of B. laterosporus YS-13 at Different Concentrations on Phosphorus Content in Rootstocks
3.3.4. Effect of B. laterosporus YS-13 at Different Concentrations on the Total Root Length of Wheat
3.3.5. Effect of B. laterosporus YS-13 at Different Concentrations on the Average Diameter of Roots
3.3.6. Effect of B. laterosporus YS-13 at Different Concentrations on the Total Root Surface Area of Roots
3.3.7. Effect of B. laterosporus YS-13 at Different Concentrations on the Total Root Volume of Roots
4. Discussion
5. Conclusions
Author Contributions
Funding
Institutional Review Board Statement
Informed Consent Statement
Data Availability Statement
Acknowledgments
Conflicts of Interest
Appendix A
| Source | Sum of Squares | df | Mean Square | F | p |
|---|---|---|---|---|---|
| Model | 2.35 | 8 | 0.2935 | 15.87 | 0.0221 * |
| X1-Glucose | 0.8533 | 1 | 0.8533 | 46.13 | 0.0065 ** |
| X2-Peptone | 1.04 | 1 | 1.04 | 56.45 | 0.0049 ** |
| X3-Sodium chloride | 0.1045 | 1 | 0.1045 | 5.65 | 0.0979 |
| X4-Temperature | 0.0096 | 1 | 0.0096 | 0.5207 | 0.5227 |
| X5-Initial pH | 0.2700 | 1 | 0.2700 | 14.59 | 0.0316 * |
| X6-Amount of inoculum | 0.0048 | 1 | 0.0048 | 0.2595 | 0.6456 |
| X7-Agitation speed | 0.0056 | 1 | 0.0056 | 0.3045 | 0.6195 |
| X8-Cultivation time | 0.0560 | 1 | 0.0560 | 3.03 | 0.1802 |
| Source | Sum of Squares | df | Mean Square | F | p |
|---|---|---|---|---|---|
| model | 3.59 | 9 | 0.3994 | 144.82 | <0.0001 ** |
| X1 | 0.5151 | 1 | 0.5151 | 186.78 | <0.0001 ** |
| X2 | 0.5101 | 1 | 0.5101 | 184.94 | <0.0001 ** |
| X5 | 0.1128 | 1 | 0.1128 | 40.91 | 0.0004 ** |
| X1X2 | 0.1260 | 1 | 0.1260 | 45.70 | 0.0003 ** |
| X1X5 | 0.0081 | 1 | 0.0081 | 2.94 | 0.1303 |
| X2X5 | 0.0056 | 1 | 0.0056 | 2.04 | 0.1963 |
| X12 | 0.4768 | 1 | 0.4768 | 172.88 | <0.0001 ** |
| X22 | 0.7043 | 1 | 0.7043 | 255.39 | <0.0001 ** |
| X2 | 0.8968 | 1 | 0.8968 | 325.17 | <0.0001 ** |
| Residua | 0.0193 | 7 | 0.0028 | ||
| Lack of Fit | 0.0054 | 3 | 0.0018 | 0.5211 | 0.6904 |
| Pure Error | 0.0139 | 4 | 0.0035 | ||
| Cor Total | 3.61 | 16 |
References
- Yi, F.H.; Suslov, D.; Espen, L.; Schiavone, M.; Rautengarten, C.; Griess-Osowsk, A.; Voiniciuc, C.; Poirier, Y. cis-Golgi phosphate transporters harboring an EXS domain are essential for plant growth and development. Plant Physiol. 2023, 192, 1000–1015. [Google Scholar] [CrossRef]
- Yu, F.Y.; Li, W.; Gao, X.K.; Li, P.; Fu, Y.H.; Yang, J.Y.; Li, Y.J.; Chen, H.; Zhou, W.L.; Wang, X.G.; et al. Genotype difference in the physiological characteristics of phosphorus acquisition by wheat seedlings in alkaline soils. Plant Soil Environ. 2020, 66, 506–512. [Google Scholar] [CrossRef]
- Nayak, A.K.; Sharma, D.K.; Singh, C.P.; Mishra, V.K.; Singh, G.; Swarup, A. Diagnosis and recommendation integrated system approach for nitrogen, phosphorus, potassium, and zinc foliar diagnostic norms for aonla in Central Indo-Gangetic plains. J. Plant Nutr. 2022, 34, 547–556. [Google Scholar] [CrossRef]
- Meng, L.Z.; Chen, Y.H.; Tang, L.Y.; Sun, X.F.; Huo, H.X.; He, Y.X.; Huang, Y.N.; Shao, Q.; Pan, S.; Li, Z. Effects of temperature-related changes on charred bone in soil: From P release to microbial community. Curr. Res. Microb. Sci. 2024, 6, 100221. [Google Scholar] [CrossRef]
- Philippe, N.; Anna, L.; Clemens, R.; Manfred, B.; Alecos, D.; Martiya, S. GEMAS: Phosphorus in European agricultural soil—Sources versus sinks at the continental-scale—The geological perspective. Sci. Total Environ. 2024, 930, 172524. [Google Scholar] [CrossRef]
- Ejaz, S.; Batool, S.; Anjum, M.A.; Naz, S.; Qayyum, M.F.; Naqqash, T.; Shah, K.H.; Ali, S. Effects of inoculation of root-associative Azospirillum and Agrobacterium strains on growth, yield and quality of pea (Pisum sativum L.) grown under different nitrogen and phosphorus regimes. Sci. Hortic. 2020, 270, 109401. [Google Scholar] [CrossRef]
- Yuan, K.X.; Zhang, H.; Yu, C.J.; Luo, N.; Yan, J.J.; Zheng, S.L.; Hu, Q.; Zhang, D.H.; Kou, L.Q.; Meng, X.B.; et al. Low phosphorus promotes NSP1–NSP2 heterodimerization to enhance strigolactone biosynthesis and regulate shoot and root architecture in rice. Mol. Plant 2023, 16, 1811–1831. [Google Scholar] [CrossRef]
- Jiang, T.Y.; Yu, T.; Qi, H.B.; Li, F.Y.; Yang, Z.F. Analysis of phosphorus and sulfur effect on soil selenium bioavailability based on diffusive gradients in thin films technique and sequential extraction. Chemosphere 2022, 302, 134831. [Google Scholar] [CrossRef]
- Zhuang, H.; Wang, J. Research progress of phosphorus fertilizer utilization efficiency in soil. Front. Sustain. Cities 2023, 3, 48–53. [Google Scholar] [CrossRef]
- Alam, K.; Barman, M.; Datta, S.P.; Annapurna, K.; Shukla, L.; Ray, P. Application of phosphate solubilizing fungi and lime altered the soil inorganic phosphorus fractions in an Ultisol of north-eastern India. Soil Sci. Plant Nutr. 2022, 68, 409–420. [Google Scholar] [CrossRef]
- Nieminen, M.; Laurén, A.; Hökkä, H.; Sarkkola, S.; Koivusalo, H.; Pennanen, T. Recycled iron phosphate as a fertilizer raw material for tree stands on drained boreal peatlands. For. Ecol. Manag. 2011, 261, 105–110. [Google Scholar] [CrossRef]
- Raza, S.; Kuzyakov, Y.; Zhou, J.B. Facts to acidification-induced carbonate losses from Chinese croplands. Glob. Change Biol. 2020, 27, 7–10. [Google Scholar] [CrossRef] [PubMed]
- Javeed, H.M.R.; Qamar, R.; Rehman, A.U.; Ali, M.; Rehman, A.; Farooq, M.; Zamir, S.I.; Nadeem, M.; Cheema, M.; Shehzad, M.; et al. Improvement in soil characteristics of sandy loam soil and grain quality of spring maize by using phosphorus solublizing bacteria. Sustainability 2019, 11, 7049. [Google Scholar] [CrossRef]
- Lin, P.; Cai, B.Y. Phosphate-solubilizing bacteria: Advances in their physiology, molecular mechanisms and microbial community effects. Microorganisms 2023, 11, 2904. [Google Scholar] [CrossRef]
- Kour, D.; Rana, K.L.; Kaur, T.; Yadav, N.; Yadav, A.N.; Kumar, M.; Kumar, V.; Dhaliwal, H.S.; Saxena, A.K. Biodiversity, current developments and potential biotechnological applications of phosphorus-solubilizing and—Mobilizing microbes: A review. Pedosphere 2021, 31, 43–75. [Google Scholar] [CrossRef]
- Dandessa, C.; Bacha, K. Review on Role of phosphate solubilizing microorganisms in sustainable agriculture. Int. J. Curr. Res. Acad. Rev. 2018, 6, 48–55. [Google Scholar] [CrossRef]
- Lacava, P.T.; Machado, P.C.; Andrade, P.H.M.D. Phosphate solubilization by endophytes from the tropical plants. Sustain. Dev. Biodivers. 2021, 3, 207–226. [Google Scholar] [CrossRef]
- Javaid, S.; Mushtaq, S.; Mumtaz, M.Z.; Rasool, G.; Naqqash, T.; Afzal, M.; Mushtaq, U.; Ali, H.M.; Akhtar, M.; Abbas, G.; et al. Mineral solubilizing rhizobacterial strains mediated biostimulation of rhodes grass seedlings. Microorganisms 2023, 11, 2543. [Google Scholar] [CrossRef]
- Green, M.R.; Sambrook, J. Molecular Cloning: A Laboratory Manual: Three-Volume Set—AbeBooks-Michael, R., 4th ed.; Cold Spring Harbor Laboratory Press: New York, NY, USA, 2012; pp. 1508–1513. [Google Scholar]
- Deng, M.K.; Sun, Y.; Han, W.Q. Methods of identification of bacteria. Prog. Biomed. Eng. 2014, 35, 84–88. [Google Scholar]
- Gonfa, T.; Negessa, A.K.; Bulto, A.O. Isolation, screening, and identification of chitinase-producing bacterial strains from riverbank soils at Ambo, Western Ethiopia. Heliyon 2023, 9, e21643. [Google Scholar] [CrossRef]
- Mo, P.; Wu, C.; Han, R.N.; Chen, Z.Y.; Luo, Y.; Xie, P.; Li, L.; Wang, Y. Streptomyces cathayae sp. nov., an endophytic actinobacterium from the root tissue of Cathaya argyrophylla. Antonie Van Leeuwenhoek 2024, 117, 31. [Google Scholar] [CrossRef] [PubMed]
- Liu, X.A.; Qi, G.B.; Wu, M.; Pan, Y.T.; Liu, B. Universal fluorescence light-up gram-staining technique for living bacterial differentiation. Chem. Mater. 2021, 33, 9213–9220. [Google Scholar] [CrossRef]
- Lyu, N.; Potluri, P.R.; Rajendran, V.K.; Wang, Y.L.; Sunna, A. Multiplex detection of bacterial pathogens by PCR/SERS assay. Analyst 2024, 149, 2898–2904. [Google Scholar] [CrossRef]
- Zhang, L.; Zhang, S.Y.; Wang, Y.L.; Li, G.; Yang, D.L.; Zhao, J.N. Isolation and identification of efficient organophosphate-dissolving bacteria from rhizosphere soil of P-efficient transgenic rice OsPT4. J. Agro-Environ. Sci. 2022, 41, 834–840. [Google Scholar] [CrossRef]
- Verma, M.P.; Pandove, G.; Oberoi, H.K.; Kaur, S.; Kalia, A.; Singh, D.K.; Kaur, J. Effect of seed biopriming with liquid bacterial inoculants on quality of forage oats (Avena sativa). Indian J. Agric. Sci. 2023, 93, 576–578. [Google Scholar] [CrossRef]
- Le, D.N.Q.; Hessel, V.; Robertson, K.; Escribà-Gelonch, M.; Marschner, P.; Tran, N.N.; Williams, P.M.; Fisk, I.D. Microflow synthesis of a formulation of phosphorus fertiliser to enhance the P content in soil and P uptake in wheat. Green Chem. 2023, 25, 9422–9437. [Google Scholar] [CrossRef]
- Hurtado, M.D.P.; Carmona, S.E.V.; Delgado, D.A. Automated modification of the molybdenum blue colorimetric method for phosphorus determination in soil extracts. Commun. Soil Sci. Plant Anal. 2008, 39, 2250–2257. [Google Scholar] [CrossRef]
- Wu, L.L.; Chu, T.T.; Xu, F.; Shi, X.Y. Uncertainty analysis of plate colony counting method in practice. Ind. Microbiol. 2025, 55, 181–183. [Google Scholar]
- Luo, L.; Wang, G.L.; Wang, Z.M.; Ma, J.; He, Y.; He, J.S.; Wang, L.L.; Liu, Y.; Xiao, H.; Xiao, Y.L.; et al. Optimization of Fenton process on removing antibiotic resistance genes from excess sludge by single-factor experiment and response surface methodology. Sci. Total Environ. 2021, 788, 147889. [Google Scholar] [CrossRef]
- Fu, S.B.; He, Y.J.; Tan, M.C.; Cao, Q.; Xu, H.L.; Yang, Z.D.; Meng, Q.F. The liquid fermentation process for mycelia of Poria cocos (agaricomycetes) by single-factor experimentation and response surface methodology. Int. J. Med. Mushrooms 2024, 26, 41–51. [Google Scholar] [CrossRef]
- Xue, Y.F.; Sun, Q.; Feei, Z.; Wang, L.; Kong, L.M. Preliminary study on protein isolation process of walnut dregs by single factor experiments and response surface method. J. Food Meas. Charact. 2020, 15, 1310–1316. [Google Scholar] [CrossRef]
- Hu, Q.P.; Liu, R.X.; Liu, J.X. Effects of Bacillus subtilis QM3 on germination and antioxidant enzymes activities of wheat seeds under salt stress. Open Access Libr. J. 2019, 6, 1–9. [Google Scholar] [CrossRef]
- Yun, J.T.; Kim, H.; Moon, J.H.; Won, S.J.; Choub, W.; Choi, S.I.; Ajuna, H.B.; Lee, P.S.H.; Ahn, Y.S. Antifungal and plant-growth promotion effects of Bacillus velezensis when applied to coastal to pine (Pinus thunbergii Parl.) seedlings. Forests 2023, 15, 62. [Google Scholar] [CrossRef]
- Wang, Y.; Wu, Z.H.; Wang, Z.W.; Du, H.; Xiao, S.; Lin, L.; Wang, Z. Analyses of the antibiofilm activity of o-Phenanthroline monohydrate against Enterococcus faecalis and Staphylococcus aureus and the mechanisms underlying these effects. ACS Infect. Dis. 2024, 10, 638–649. [Google Scholar] [CrossRef]
- Chandana, M.; Qureshi, A.A.; Sharma, S.H.K.; Triveni, S. Influence of different doses and methods of phosphorous solubilizing bacteria and phosphorus levels on the phosphorus solubilizing bacteria population and phosphorous use efficiency in sunflower and chickpea. Int. J. Environ. Clim. Change 2022, 12, 953–959. [Google Scholar] [CrossRef]
- McKie, V.A.; McCleary, B.V. A novel and rapid colorimetric method for measuring total phosphorus and phytic acid in foods and animal feeds. J. AOAC Int. 2016, 99, 738–743. [Google Scholar] [CrossRef]
- Song, P.; Wang, Z.L.; Sun, X.X.; He, Y.L.; Zhang, W.J.; Yang, Y.Q.; Zhao, P.Y. Screening, Identification, and fermentation of a biocontrol strain against peony southern blight and extraction of secondary metabolites. Agriculture 2024, 14, 833. [Google Scholar] [CrossRef]
- Lu, Z.M.; He, S.; Kashif, M.; Zhang, Z.F.; Mo, S.M.; Su, G.J.; Du, L.F.; Jiang, C.J. Effect of ammonium stress on phosphorus solubilization of a novel marine mangrove microorganism Bacillus aryabhattai NM1-A2 as revealed by integrated omics analysis. BMC Genom. 2023, 24, 327–338. [Google Scholar] [CrossRef]
- Zhao, Y.; Wu, P.P. Screening and preliminary identification of soil potassium and phosphorus-hydrolyzing bacteria WP1-3. In E3S Web of Conferences; EDP Sciences: Les Ulis, France, 2021; p. 02026. [Google Scholar] [CrossRef]
- Sun, H.G.; Zhang, F.S. Growth response of wheat roots to phosphorus deficiency. J. Integr. Plant Biol. 2000, 42, 913–919. [Google Scholar]
- Yadav, A.; Chauhan, R.M.; Yadav, K. Halotolerant phosphate solubilizing bacteria as growth promoter for mung bean, pea and wheat crops. Int. J. Plant Soil Sci. 2023, 35, 239–247. [Google Scholar] [CrossRef]
- Li, Z.H.; Peng, J.J.; Yang, K.; Zhang, Y.Y.; Chen, Q.L.; Zhu, Y.G.; Li, C. Single-cell exploration of active phosphate-solubilizing bacteria across diverse soil matrices for sustainable phosphorus management. Nat. Food 2024, 5, 673–683. [Google Scholar] [CrossRef] [PubMed]
- Li, C.P.; Shi, W.C.; Wu, D.; Tian, R.M.; Wang, B.; Lin, R.M.; Zhou, B.; Gao, Z. Biocontrol of potato common scab by Brevibacillus laterosporus BL12 is related to the reduction of pathogen and changes in soil bacterial community. Biol. Control 2021, 153, 104496. [Google Scholar] [CrossRef]
- Liu, Y.C.; Zai, X.Y.; Weng, G.Y.; Ma, X.Y.; Deng, D. Brevibacillus laterosporus: A probiotic with important applications in crop and animal production. Microorganisms 2024, 12, 564. [Google Scholar] [CrossRef]
- Lyng, M.; Kovács, A.T. Frenemies of the soil: Bacillus and Pseudomonas interspecies interactions. Trends Microbiol. 2023, 31, 845–857. [Google Scholar] [CrossRef]
- Fan, B.Q.; Jin, G.Y.; Ge, C. lsolation of penicillium oxalicum and lts effect on solubilization ofinsoluble phosphate under different conditions. Sci. Agric. Sin. 2002, 35, 525–530. [Google Scholar] [CrossRef]
- Alonazi, M.; Krayem, N.; Alzahrani, A.; Horchani, H.; Bacha, A.B. Novel phospholipase C with high catalytic activity from a Bacillus stearothermophilus strain: An ideal choice for the oil degumming process. Processes 2023, 11, 3310. [Google Scholar] [CrossRef]
- Nakazawa, Y.; Uchino, M.; Sagane, Y.; Sato, H.; Tanaka, K. Isolation and characterization of actinomycetes strains that produce phospholipase D having high transphosphatidylation activity. Microbiol. Res. 2006, 164, 43–48. [Google Scholar] [CrossRef]
- García-Sánchez, M.; Bertrand, I.; Barakat, A.; Zeroual, Y.; Oukarroum, A.; Plassard, C. Improved rock phosphate dissolution from organic acids is driven by nitrate assimilation of bacteria isolated from nitrate and CaCO3-rich soil. PLoS ONE 2023, 18, e0283437. [Google Scholar] [CrossRef]
- Shuttleworth, K.L.; Richard, F.U. Sorption of heavy metals to the filamentous bacterium Thiothrix strain A1. Appl. Environ. Microbiol. 1993, 59, 1274–1282. [Google Scholar] [CrossRef]
- Wang, C.; Yang, C.T.; Liu, T.; Tian, P.F.; Zhang, S.Q.; Dai, X.Z.; Igarashi, Y.; Luo, F. Revealing the phosphate-solubilizing characteristics and mechanisms of the plant growth-promoting bacterium Agrobacterium deltaense C1. J. Appl. Microbiol. 2023, 135, 284. [Google Scholar] [CrossRef]
- Wang, X.L.; Qiu, S.Y.; Zhou, S.Q.; Xu, Z.H.; Liu, X.T. Phosphate-solubilizing capacity of Paecilomyces lilacinus PSF7 and optimization using response surface methodology. Microorganisms 2023, 11, 454. [Google Scholar] [CrossRef] [PubMed]
- Elhaissoufi, W.; Ibnyasser, A.; Haddine, M.; Zeroual, Y.; Ghani, R.; Barakat, A.; Rchiad, Z.; Ghoulam, C.; Bargaz, A. Screening of potential phosphate solubilizing bacteria inoculants should consider the contrast in phosphorus bio-solubilization rate along with plant growth promotion and phosphorus use efficiency. J. Appl. Microbiol. 2022, 134, lxac077. [Google Scholar] [CrossRef] [PubMed]
- Fan, J.Y.; Qu, J.Z.; Wang, D.; Chen, J.; Du, G.C.; Fang, F. Synergistic fermentation with functional microorganisms improves safety and quality of traditional Chinese fermented foods. Foods 2023, 12, 2892. [Google Scholar] [CrossRef] [PubMed]
- Ziegler, A.L.; Manchanda, A.; Stumm, M.D.; Blank, L.M.; Mitsos, A. Simultaneous design of fermentation and microbe. Aiche J. 2024, 70, e18501. [Google Scholar] [CrossRef]
- Mehrshad, N.; Ahmad, T.A.; Ali, A.; Ahmad, A.M.; Aliasghar, T. Optimization of biohydrogen production from microalgae by response surface methodology (RSM). Energy 2022, 253, 124059. [Google Scholar] [CrossRef]
- Kaltenbach, H.M. Experimental Optimization with response surface methods. In Statistical Design and Analysis of Biological Experiments; Kaltenbach, H.M.L., Ed.; Springer: Cham, Switzerland, 2021; pp. 241–260. [Google Scholar]
- Biswas, S.S.; Biswas, D.R.; Ghosh, A.; Sarkar, A.; Das, A.; Roy, T. Phosphate solubilizing bacteria inoculated low-grade rock phosphate can supplement P fertilizer to grow wheat in sub-tropical inceptisol. Rhizosphere 2022, 23, 100556. [Google Scholar] [CrossRef]
- Li, S.X.; Wang, Z.H.; Stewart, B.A. Differences of some leguminous and nonleguminous crops in utilization of soil phosphorus and responses to phosphate fertilizers. Adv. Agron. 2011, 110, 125–249. [Google Scholar] [CrossRef]
- Grzebisz, W.; Niewiadomska, A.; Potarzycki, J.; Andrzejewska, A. Phosphorus hotspots in crop plants production on the farm-mitigating critical factors. Agronomy 2024, 14, 200. [Google Scholar] [CrossRef]
- Babulu, N.; Devi, N.S.; Singh, A.H.; Devi, K.N.; Singh, N.G.; Lalmalsawma, R. Effect of rock phosphate, single super phosphate and phosphorus solubilizing bacteria on phosphorus concentration and dry matter yield of paddy. Int. J. Plant Soil Sci. 2022, 34, 1771–1776. [Google Scholar] [CrossRef]
- Li, R.; Li, J.M.; Li, H.F.; Guo, Z.H.; Lv, Y.D. Inoculating exogenous bacterium Brevibacillus laterosporus ZR-11 at maturity stage accelerates composting maturation by regulating physicochemical parameters and indigenous bacterial community succession. Environ. Sci. Pollut. Res. 2023, 30, 110888–110900. [Google Scholar] [CrossRef]
- Świątczak, J.; Kalwasińska, A.; Wojciechowska, A.; Brzezinska, M.S. Physiological properties and genomic insights into the plant growth-promoting rhizobacterium Brevibacillus laterosporus K75 isolated from maize rhizosphere. J. Sci. Food Agric. 2022, 103, 1432–1441. [Google Scholar] [CrossRef]

| Strain YS-13 | D (mm) | d (mm) | D/d | Available Phosphorus (mg L−1) |
|---|---|---|---|---|
| Calcium phytate | 18.59 ± 0.44 b | 8.89 ± 0.68 b | 2.09 | 17.05 ± 3.43 b |
| Lecithin | 23.34 ± 2.20 a | 9.97 ± 0.88 a | 2.34 | 21.24 ± 4.71 a |
| Calcium phosphate | 11.33 ± 0.27 c | 6.59 ± 0.65 c | 1.63 | 11.73 ± 2.26 c |
| Iron phosphate | 11.17 ± 1.32 c | 9.31 ± 0.70 ab | 1.20 | 6.67 ± 2.09 d |
| Strain YS-13 | Characteristics |
|---|---|
| Shape and surface characteristics | Circular or oval, with a raised center |
| Transparency and glossiness | Non-glossy and semi-transparent |
| Edge and color | Smooth and regular edges, yellow-brown in color |
| Cell morphology | Short and thick rod-shaped, with blunt and rounded ends |
| Gram staining | Gram-positive during the logarithmic phase; Gram-negative during the late stationary phase and the decline phase |
| Spore morphology and location | Oval-shaped, subterminally located |
| Indicator | Strain YS-13 | |
|---|---|---|
| Catalase reaction | + | |
| Strictly aerobic | − | |
| Methyl red reaction | + | |
| Voges–Proskauer (V-P) reaction | − | |
| Nitrate reduction | + | |
| Indole production | − | |
| Citrate utilization | − | |
| Starch hydrolysis | + | |
| Casein hydrolysis | + | |
| H2S | − | |
| Sugar alcohol fermentation | Glucose | + |
| Lactose | − | |
| Mannitol | + | |
| Gas production from glucose | − | |
| Salt tolerance | 2% NaCl | + |
| 5% NaCl | − | |
| 7% NaCl | − | |
| Growth temperature | 45 °C | + |
| 65 °C | − | |
| Source | Fermentation Conditions | Level | |
|---|---|---|---|
| −1 | +1 | ||
| X1 | Glucose concentration (g L−1) | 4 | 10 |
| X2 | Peptone concentration (g L−1) | 4 | 10 |
| X3 | Sodium chloride concentration (g L−1) | 0.1 | 0.5 |
| X4 | Temperature (°C) | 30 | 36 |
| X5 | Initial pH | 6 | 8 |
| X6 | Amount of inoculum (%) | 4 | 8 |
| X7 | Agitation speed (r min−1) | 1.5 | 4.5 |
| X8 | Cultivation time (h) | 24 | 48 |
| Assay | Variable Levels | Number of Live Bacteria (×108 CFU mL−1) | |||||||
|---|---|---|---|---|---|---|---|---|---|
| X1 | X2 | X3 | X4 | X5 | X6 | X7 | X8 | ||
| 1 | 1 | 1 | 1 | −1 | −1 | −1 | 1 | 1 | 4.2 |
| 2 | −1 | −1 | −1 | −1 | −1 | 1 | −1 | −1 | 3.1 |
| 3 | 1 | −1 | −1 | −1 | −1 | 1 | −1 | 1 | 4.24 |
| 4 | 1 | −1 | 1 | 1 | −1 | 1 | 1 | −1 | 3.44 |
| 5 | 1 | −1 | −1 | −1 | 1 | −1 | 1 | −1 | 3.67 |
| 6 | −1 | 1 | 1 | −1 | 1 | 1 | 1 | −1 | 3.7 |
| 7 | 1 | −1 | 1 | 1 | 1 | −1 | −1 | 1 | 3.84 |
| 8 | −1 | 1 | 1 | 1 | −1 | −1 | −1 | −1 | 3.47 |
| 9 | 1 | 1 | −1 | 1 | 1 | 1 | −1 | −1 | 4.69 |
| 10 | −1 | −1 | 1 | −1 | 1 | 1 | −1 | 1 | 3.4 |
| 11 | −1 | 1 | −1 | 1 | 1 | −1 | 1 | 1 | 4.08 |
| 12 | −1 | −1 | −1 | 1 | −1 | 1 | 1 | 1 | 3.2 |
| Assay | X1 (g L−1) | X2 (g L−1) | X5 | Number of Live Bacteria (×108 CFU mL−1) |
|---|---|---|---|---|
| 1 | 4 | 4 | 6 | 3.37 |
| 2 | 5.5 | 5.5 | 6.5 | 4.12 |
| 3 | 7 | 7 | 7 | 5.54 |
| 4 | 8.5 | 8.5 | 7.5 | 6.11 |
| 5 | 10 | 10 | 8 | 5.84 |
| Assay | Variable Levels | Number of Live Bacteria (×108 CFU mL−1) | ||
|---|---|---|---|---|
| X1 | X2 | X5 | ||
| 1 | 0 | 0 | 0 | 6.35 |
| 2 | 1 | 0 | –1 | 5.72 |
| 3 | 0 | 0 | 0 | 6.24 |
| 4 | –1 | 0 | 1 | 5.43 |
| 5 | 1 | 1 | 0 | 5.88 |
| 6 | –1 | 0 | –1 | 5.11 |
| 7 | 0 | 1 | –1 | 5.65 |
| 8 | 0 | 0 | 0 | 6.39 |
| 9 | –1 | –1 | 0 | 4.93 |
| 10 | 0 | 1 | 1 | 5.82 |
| 11 | –1 | 1 | 0 | 5.74 |
| 12 | 1 | –1 | 0 | 5.78 |
| 13 | 0 | 0 | 0 | 6.36 |
| 14 | 0 | –1 | 1 | 5.34 |
| 15 | 0 | –1 | –1 | 5.02 |
| 16 | 0 | 0 | 0 | 6.3 |
| 17 | 1 | 0 | 1 | 5.86 |
Disclaimer/Publisher’s Note: The statements, opinions and data contained in all publications are solely those of the individual author(s) and contributor(s) and not of MDPI and/or the editor(s). MDPI and/or the editor(s) disclaim responsibility for any injury to people or property resulting from any ideas, methods, instructions or products referred to in the content. |
© 2025 by the authors. Licensee MDPI, Basel, Switzerland. This article is an open access article distributed under the terms and conditions of the Creative Commons Attribution (CC BY) license (https://creativecommons.org/licenses/by/4.0/).
Share and Cite
Zhang, W.; Sun, X.; Wang, Z.; Li, J.; Zhang, Y.; Zhang, W.; Zhang, J.; Cheng, X.; Song, P. Screening, Identification, and Fermentation of Brevibacillus laterosporus YS-13 and Its Impact on Spring Wheat Growth. Microorganisms 2025, 13, 1244. https://doi.org/10.3390/microorganisms13061244
Zhang W, Sun X, Wang Z, Li J, Zhang Y, Zhang W, Zhang J, Cheng X, Song P. Screening, Identification, and Fermentation of Brevibacillus laterosporus YS-13 and Its Impact on Spring Wheat Growth. Microorganisms. 2025; 13(6):1244. https://doi.org/10.3390/microorganisms13061244
Chicago/Turabian StyleZhang, Wenjing, Xingxin Sun, Zele Wang, Jiayao Li, Yuanzhe Zhang, Wei Zhang, Jun Zhang, Xianghan Cheng, and Peng Song. 2025. "Screening, Identification, and Fermentation of Brevibacillus laterosporus YS-13 and Its Impact on Spring Wheat Growth" Microorganisms 13, no. 6: 1244. https://doi.org/10.3390/microorganisms13061244
APA StyleZhang, W., Sun, X., Wang, Z., Li, J., Zhang, Y., Zhang, W., Zhang, J., Cheng, X., & Song, P. (2025). Screening, Identification, and Fermentation of Brevibacillus laterosporus YS-13 and Its Impact on Spring Wheat Growth. Microorganisms, 13(6), 1244. https://doi.org/10.3390/microorganisms13061244
